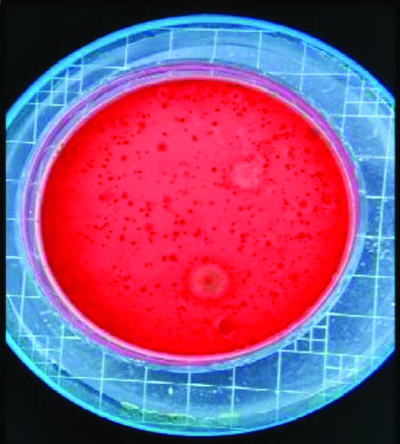
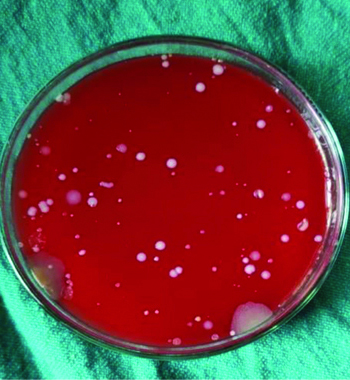
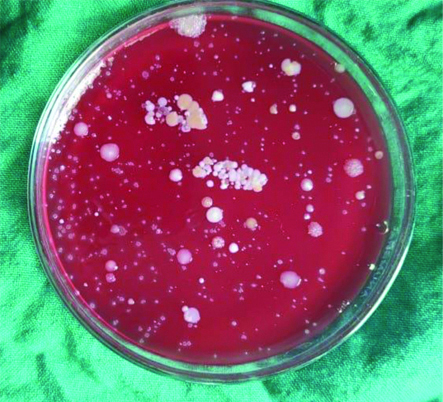

Mechanical plaque removal, which is the main cornerstone for attaining periodontal health, not only eliminates supra- and subgingival deposits but also generates aerosols. Aerosols, which are a combination of organic fluids and inorganic substances, have a diameter ranging from 0.2 to 2.0 microns [1]. These aerosols may lead to respiratory health issues, including Severe Acute Respiratory Distress Syndrome (SARS). To combat these aerosols, which have a diameter of less than five microns, the use of Personal Protective Equipment (PPE) along with high-volume suction has been highly recommended and advocated [2]. Along with these precautionary measures, antimicrobial rinses such as preprocedural mouthwashes have been tried and tested over the last few decades [2,3].
Among the innumerable mouth rinses commercially available, chlorhexidine is considered the gold standard, not only due to its efficacy to combat a wide array of microorganisms but also because of its substantivity [4,5]. On the other hand, herbal preparations have enmassed the world of chemical plaque control with a variety of compositions and combinations, stating their uniqueness combating biofilm and enhancing oral health [6].
Lemongrass oil is one such essential oil extracted from Andropogon, a member of the Poaceae family [3]. It possesses significant antibacterial, antifungal, antioxidant, anti-inflammatory, and antipyretic effects, comparable to those of penicillin in terms of effectiveness [7]. Due to its unique properties, lemongrass oil has been used as a mouthwash in some studies, although it has not been extensively documented. However, to the best of authors knowledge, lemongrass oil has not been tested for its efficacy as a preprocedural mouth rinse to date. The present study is unique and novel in its own way.
Previous studies on 0.25% lemongrass oil have been published in the literature regarding its effectiveness as a mouthwash [3,8]. However, the role of lemongrass oil as a preprocedural mouth rinse has never been tested or demonstrated in any previous studies. Hence, the present study is the first to evaluate its efficacy as a preprocedural rinse as well as compare it with the gold standard, chlorhexidine.
Materials and Methods
This single-centre double-blinded randomised controlled parallel design split-mouth clinical trial was planned in the Department of Periodontics among patients attending Vishnu Dental College and Hospital in Bhimavaram, Andhra Pradesh, India, with periodontitis stage II or III and Grade B according to the Academy of Periodontology (AAP) 2017 classification [9].
The protocol was approved by the Ethics Committee of the Institutional review board (Vishnu Dental College and Hospital, Bhimavaram, Andhra Pradesh, India) under project No. IECVDC/22/PG01/PI/IVV/41, and the study was registered under Clinical Trial Registry, India (CTRI No: CTRI/2022/12/047989).
Sample size calculation: The present study included 56 patients, calculated using G-Power software version 3.1.9.5, with an α error of 0.05, a power of 80%, and an effect size of 0.77.
Patients with periodontitis stage II or III and Grade B according to the AAP 2017 classification-i.e., Stage II or III with an interdental Clinical Attachment Level (CAL) >5 mm, radiographic bone loss extending till the middle third and beyond, and probing depth ≥6 mm-were recruited from the Outpatient Department of the Department of Periodontics at Vishnu Dental College and Hospital, Bhimavaram, India. The study was conducted over a period of 40 days.
Inclusion criteria: The inclusion criteria for the study were patients with a minimum of 20 permanent teeth; a mean plaque score of 2.0 to 3.0 [10]; four or more sites with pocket probing depth; non smokers; and systemically healthy patients.
Exclusion criteria: Patients who underwent oral prophylaxis within the last three months or were under systemic antibiotics were excluded. Pregnant and lactating women, as well as those with five or more carious lesions requiring immediate restorative therapy, were also considered ineligible.
Study Procedure
Patients who met the inclusion and exclusion criteria were chosen for the study, and the nature of the procedure, as well as any discomforts or risks, was clearly explained. A signed informed consent was obtained prior to the initiation of the study. A total of 56 subjects were randomly assigned to two groups: Group A received 0.2% lemongrass oil, and Group B received 0.2% Chlorhexidine, using a simple coin toss method. The split-mouth design was executed in the study, where the 1st and 4th quadrants were devoid of usage of preprocedural mouth rinse prior to oral prophylaxis. On the other hand the 2nd and 3rd quadrants were treated with a preprocedural mouth rinse before scaling. This design enabled us to evaluate and compare the efficacy of lemongrass oil with chlorhexidine as preprocedural mouth rinses.
In both groups, oral prophylaxis was performed for the 1st and 4th quadrants without using any preprocedural mouth rinse. Patients rinsed for one minute with 10 mL of either 0.2% Chlorhexidine (CHX) or 0.2% lemongrass oil. Participants in Group A received the 0.2% lemongrass oil mouth rinse, while those in Group B received the 0.2% chlorhexidine mouth rinse. The aerosols created during prophylaxis before the use of the preprocedural mouth rinse were exposed to blood agar plates. The participants were given a preprocedural rinse, the clinician performed scaling for the 2nd and 3rd quadrants immediately. The aerosols created during prophylaxis after the use of the preprocedural mouth rinse were also exposed to blood agar plates.
Clean agar plates were exposed to the aerosols created during oral prophylaxis after the preprocedural mouth rinse. Ultrasonic scaling was performed using the Newtron P5XS handpiece on the patients for all quadrants, with a duration of 10 minutes per quadrant. One agar plate was used for two quadrants in each patient to collect airborne particles, and it was positioned on the patient’s chest to be assessed for each treatment group.
The average distance was approximately 12 inches from the patient’s mouth to the agar plate [Table/Fig-1]. The blood agar plates were incubated at 37°C for 36 hours after the samples were collected. The number of Colony Forming Units (CFUs) that grew on each plate was sent to the Microbiology Department of Vishnu Dental College and Hospital for counting the CFUs [Table/Fig-2]. CFUs with and without rinse were assessed and studied.
Agar plate on patients chest at 12 inches from the oral cavity.

Colony counting done by using colony counter.
All treatment procedures were carried out in the same closed operatory. The operatory was fumigated immediately after the completion of each patient’s treatment, thereby ensuring disinfection, which provides a dual benefit for both the clinician and the patient. Oral prophylaxis was performed on all study participants in a standardised dental chair with controlled frequency and water pressure during the treatment procedures. [Table/Fig-3] shows the CONSORT flow diagram.

Statistical Analysis
For statistical analyses, individual measurements were summarised within each individual and then analysed. The software IBM SPSS version 20.0 (IBM SPSS Statistics for Windows version 20, Armonk, NY, USA) was used for data analysis. Intragroup comparisons for both groups were made using paired t-tests, while independent t-tests were used to compare the differences between the two groups. p-values less than 0.05 were considered statistically significant.
A greater reduction in the mean Plaque Index (PI) and Gingival Index (GI) scores was recorded in the day followed by 0.2% chlorhexidine mouthwash group followed by oral prophylaxis-only group.
Results
In the present study, 56 patients with stage II or III periodontitis and Grade B were selected and randomly divided into two groups: one receiving lemongrass oil and the other receiving chlorhexidine, with each group comprising 28 patients. The mean plaque index indicated that all subjects participating in the study fell within the range of 2.0 to 3.0, and intergroup comparisons showed no significant difference at baseline [Table/Fig-4].
Comparison of the study variables between the two groups.
| Variable | Group | Mean±SD | Std. Error mean | t-value | p-value |
|---|
| Plaque score | Lemongrass (Group A) | 2.507±0.2403 | 0.0454 | -0.053 | 0.958 |
| Chlorhexidine (Group B) | 2.504±0.2617 | 0.0495 |
Independent samples t-test; p≤0.05 considered statistically significant
The mean CFU count in the chlorhexidine group without rinse was 259.6±26.6, while with rinse it was 140.7±22.6, which was statistically significant (p-value <0.001*) [Table/Fig-5]. In the lemongrass oil group, the CFU count without rinse was 263.50±26.9, and with rinse it was 147.18±33.82, which was also statistically significant (p-value <0.001*).
Intragroup comparison with and without preprocedural rinse.
| Groups | Group and quadrants | Mean±SD | Std. Error mean | t-value | p-value |
|---|
| Group A (0.2% Lemongrass oil) | Without rinse (1&4) | 263.50±26.999 | 5.102 | 24.6 | <0.001* |
| With rinse (2&3) | 147.18±33.828 | 6.393 |
| Group B (0.2% Chlorhexidine) | Without rinse (1&4) | 259.61±26.634 | 5.033 | 58.46 | <0.001* |
| With rinse (2&3) | 140.71±22.644 | 4.279 |
Paired t-test; p≤0.05 considered statistically significant; *denotes statistical significance
For intergroup comparisons, the p-values for both groups-those with a preprocedural rinse (Group A vs. Group B, quadrants 2 and 3) and those without a preprocedural rinse (Group A vs. Group B, quadrants 1 and 4)-were 0.40 and 0.58, respectively, both of which were not significant [Table/Fig-6]. The agar plates from the various groups has been depicated in [Table/Fig-7,8,9 and 10].
Comparison of the CFU between the two groups.
| Quadrants | Groups | Mean±SD | Std. Error mean | t-value | p-value |
|---|
| Without preprocedural rinse (1 and 4 quadrants) | Lemongrass (Group A) | 263.50±26.999 | 5.102 | -0.543 | 0.589 |
| Chlorhexidine (Group B) | 259.61±26.634 | 5.033 |
| With preprocedural rinse (2 and 3 quadrants) | Lemongrass (Group A) | 147.18±33.828 | 6.393 | -0.84 | 0.404 |
| Chlorhexidine (Group B) | 140.71±22.644 | 4.279 |
Independent samples t-test; p≤0.05 considered statistically significant
Agar plates depicting CFU’s in the lemongrass oil group (Group A) without rinse.

Agar plates depicting CFU’s in the lemongrass oil group (Group A) with rinse.
Agar plates depicting CFU’s in the chlorhexidine group (Group B) without rinse.
Agar plates depicting CFU’s in the chlorhexidine group (Group B) with rinse.

Discussion
Professional mechanical plaque removal, which forms the gold standard for preventive periodontics, is one of the most commonly executed procedures in dentistry. Aerosols are the suspension of liquid and/or solid particles in the air, generated by any act that expels oral fluids into the air (with particle sizes typically around 50 micrometers) [1,11]. These aerosols form an integral part of ultrasonic scaling. Keeping in mind the probable hazards that would be encountered, as a dental professional it’s authors sole responsibility of dental professionals to minimise these aerosols for the benefit of both the patient as well as the clinician. This necessitates the usage of preprocedural mouth rinse [12].
Over the decades, the use of chlorhexidine has been widely documented, and its role as a preprocedural mouth rinse has been substantiated. On the other hand, alternative periodontics, which encompasses the use of herbal products such as mouthwashes and dentifrices, have also been extensively utilised [13]. Essential oils are aromatic oils derived from plant materials and have been shown to possess antibacterial, antifungal, antiviral, and antioxidant properties [3,7,14]. Lemongrass oil, a type of essential oil, has the dual benefits of antioxidant and anti-inflammatory properties [8,15]. Several studies have documented the use of lemongrass oil as an anti-plaque agent; however, none have employed it as a preprocedural mouth rinse [16]. As a result, the current study aimed to assess the efficacy of a 0.2% lemongrass oil mouth rinse compared to a 0.2% CHX mouthwash as a preprocedural rinse.
The main goal of the study is to determine and compare the efficacy of lemongrass oil versus chlorhexidine as a preprocedural rinse. Subjects in the test group used lemongrass oil as a preprocedural mouth rinse, while those in the control group used chlorhexidine.
The present study found a significantly substantial reduction in bacterial CFUs in both groups. Suresh SR et al., conducted a study to compare the efficacy of preprocedural rinsing with chlorhexidine and an essential oil-containing mouth rinse in reducing the viable bacteria in dental aerosol following oral prophylaxis. They concluded that chlorhexidine is an effective primary measure for reducing aerosol cross-contamination when using dental devices in a dental set-up [17]. Verma N et al., concluded that the use of povidone-iodine as a preprocedural rinse comparatively reduced aerosol contamination compared to chlorhexidine [18]. Nayak SU et al., in a study conducted in 2020, found that herbal rinses were as effective as chlorhexidine in reduction of bacteria present in aerosols during ultrasonic scaling [1].
In contrast to the above study, Asmita AM et al., found that preprocedural rinsing with 0.2% chlorhexidine gluconate was shown to be much more effective than herbal mouth rinse in reducing aerosolised microorganisms during ultrasonic scaling [19]. Sadun AS et al., conducted a study to evaluate the effectiveness of preprocedural rinsing using an essential oils mouthwash (Listerine®) in reducing bioaerosol contamination in a dental clinic and concluded that rinsing with Listerine® was effective in reducing microorganisms in saliva and the oral cavity in general. On the other hand, lemongrass oil, which is an essential oil, has also been extensively used as a mouthwash [20].
In 2015, Dany SS et al., conducted a study to examine the anti-plaque and anti-gingivitis activity of lemongrass oil mouthwash with chlorhexidine mouthwash, concluding that lemongrass oil mouthwash can also serve as a good herbal alternative [3]. A study conducted in 2021 by Akula S et al., evaluated the anti-plaque and anti-gingivitis activity of lemongrass oil mouthwash and concluded that it can be a good herbal alternative to chlorhexidine [21]. Another study done in 2023 by Wasey F et al., compared the antiplaque and antibacterial activity of 0.25% lemongrass oil mouthwash with 0.2% chlorhexidine for treating gingivitis has shown a significant decrease in plaque and gingival indices in the lemongrass group [22]. However, no studies have been done to evaluate the effect of lemongrass oil as a preprocedural mouth rinse in reducing the microbial load in dental aerosols generated.
The present study showed that the use of both chlorhexidine and lemongrass oil-containing mouth rinse for one minute as a preprocedural rinse before ultrasonic scaling considerably reduced bacterial load and contamination in the operating room. However, present findings indicate that 0.2% chlorhexidine as a preprocedural mouth rinse is a more effective primary measure than lemongrass oil in minimising aerosol cross-contamination during ultrasonic scaling in dentistry.
Limitation(s)
The limitations of present study that should be noted are that the CFUs identified here indicate only aerobic bacteria capable of growing on blood agar plates. Viruses, anaerobic bacteria, and organisms requiring specialised media were not cultivated in present study.
Conclusion(s)
The use of a preprocedural mouth rinse effectively lowers the bacterial count in aerosols produced by ultrasonic scaling. Lemongrass oil can be used as an effective herbal substitute for chlorhexidine. However, long-term clinical trials on the efficacy of lemongrass oil as a preprocedural mouth rinse are needed, involving a larger sample size.
Independent samples t-test; p≤0.05 considered statistically significant
Paired t-test; p≤0.05 considered statistically significant; *denotes statistical significance
Independent samples t-test; p≤0.05 considered statistically significant